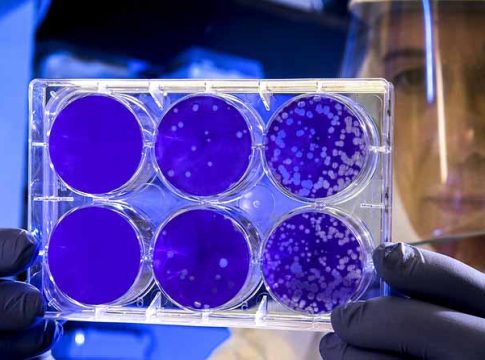

Las soluciones en bioseguridad para prevenir la expansión del coronavirus en las empresas y negocios es el eje central de Sicur Especial Covid, el primer evento híbrido online + presencial puesto en marcha por Feria de Madrid Ifema.
Desde el pasado 1 de julio, y hasta el 30 de septiembre, este evento estará disponible online y pretende favorecer la reactivación económica y la adaptación de las empresas y negocios al nuevo escenario de protección anti-covid. Mientras que los días 14 y 15 de julio tendrán lugar los actos presenciales con encuentros B2B.
En concreto, las reuniones presenciales permitirán ver los productos en directo, en un entorno seguro, y afianzar la relación comercial en un momento en el que las reuniones “cara a cara” toman especial valor.
Cerca de 50 empresas se han sumado ya a esta plataforma con una oferta centrada en bioseguridad, que abarca un amplio abanico de productos y contenidos pensados para minimizar la expansión de la pandemia, crear espacios controlados y contribuir al desarrollo de una sociedad más segura, cumpliendo con la normativa.
En este sentido, en la feria se podrán conocer interesantes soluciones integrales y avanzadas herramientas tecnologías para el control de acceso inteligente y sin contacto, innovadoras cámaras de termografía, dispositivos con reconocimiento facial y detección de mascarilla, sistemas de control de aforo para todo tipo de establecimientos, o soluciones de detección de cumplimiento de la distancia de seguridad en espacios abiertos y grandes áreas, entre otras.
No faltarán en Sicur Especial Covid lo último en sistemas de purificación de aire que no utilizan productos químicos nocivos para la salud, y soluciones que combinan varias tecnologías efectivas para limpiar el aire de patógenos y reducir el riesgo de infección.
En materia de desinfección, junto a toda una completa gama de productos higienizantes como las soluciones hidroalcohólicas hipoalergénicas, se presentan varios sistemas que proponen combatir patógenos mediante distintas aproximaciones tecnológicas, como túneles de desinfección de diferentes características.
La oferta de este evento se completa con una variada propuesta de equipos de protección individual (EPIs) y accesorios anti-covid, como mascarillas higiénicas, guantes, textiles de protección sanitaria reutilizables y homologados, termómetros y oxímetros, entre otros.
REUNIONES PRESENCIALES Y VIRTUALES
Con un formato híbrido, la plataforma Sicur Especial Covid pone en contacto a proveedores y clientes, y permite generar reuniones de manera virtual y/o presencial. De este modo, favorece una mayor visibilidad de la feria y lograr un mayor número de contactos.
La plataforma online está dotada de Inteligencia Artificial, que permite búsquedas y propone contactos con intereses coincidentes. Así, ofrece la posibilidad de generar diálogos, reuniones “one to one”, tanto virtuales como presenciales, y encuentros online de networking, además de alojar espacios formativos en la web.